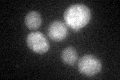
YML101C

View description
Protein of unknown function; has a CUE domain that binds ubiquitin, which may facilitate intramolecular monoubiquitination
Localization:
Intensity:
Fold change:
Significance:
-
C’ GFP library in SD

ER26.37 -
N' NOP1pr-GFP in SD

nucleus90.452 -
N' TEF2pr-mCherry in SD

ER,punctate80.5824 -
N' NATIVEpr-GFP in SD

ER34.4083 -
N' TEF2pr-VC and Cyto-VN in SD

below threshold24.7166 -
C’ GFP library in SD+DTT
ER24.810.94No -
C’ GFP library in SD+H2O2

ER33.331.26No -
C’ GFP library in Starvation Media

ER19.560.74Yes -
C’ GFP library on the background of Pup2-DaMP

ER -
C’ GFP library on the background of CCT mutant

ER21.42160.812154No
